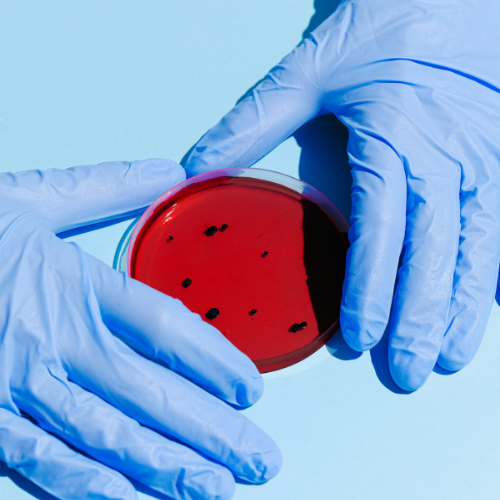

At SKAS Lab, we are a trusted pharmaceutical testing lab offering comprehensive testing services to ensure quality, safety, and regulatory compliance for both raw materials and finished pharmaceutical products.
As an NABL-accredited laboratory, SKAS Lab is among the leading pharma testing labs, conducting testing in accordance with Indian Pharmacopoeia (IP), British Pharmacopoeia (BP), United States Pharmacopoeia (USP), Japanese Pharmacopoeia (JP), and Martindale’s standards. Our cutting-edge analytical techniques and state-of-the-art instruments enable us to deliver precise and reliable results for pharmaceutical manufacturers, ensuring that products meet both domestic and international regulatory requirements.
Our testing lab covers the following finished pharmaceutical products:
- Oral Liquids & Solids – Syrups, suspensions,
emulsions, tablets, capsules, and powders
- Topical Semi-Solids – Ointments, gels, creams, and
lotions
- Ophthalmic Products – Eye drops and sterile ophthalmic
solutions
- Parenteral Products – Injectable formulations,
including IV solutions and sterile powders
- Aerosols & Inhalation Products – Metered-dose inhalers
(MDIs), dry powder inhalers (DPIs), and nebulizers
Regulatory Compliance & Quality Standards
We conduct quality evaluation as per various
pharmacopoeias, including:
- IP, USP, BP, JP, and Martindale’s standards
- Compliance with Drugs & Cosmetics Act, ISO, and WHO
guidelines
- In-house validated methods and manufacturer’s
specifications
Our commitment to precision, compliance, and reliability ensures that pharmaceutical products meet the highest industry standards.